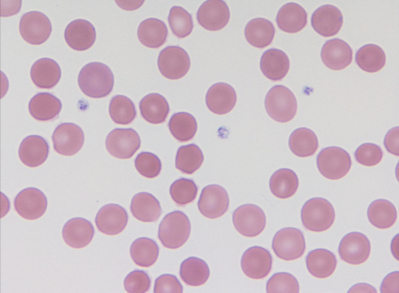
#

16 歳の男子。全身倦怠感を主訴に来院した。幼少時から顔面の黄染を家族に指摘されていた。 1 週間前に罹患した感冒を契機に全身倦怠感が出現し軽快しないため受診した。父親にも貧血があるという。
体温 36.8 ℃。脈拍 96/分、整。眼瞼結膜は貧血様で、眼球結膜に黄染を認める。 胸骨右縁第 2 肋間を最強点とするLevine 2/6 の収縮期雑音を聴取する。
血液所見:赤血球 245 万、Hb 6.5 g/dL、Ht 23 %、白血球 4,200、血小板 32 万。血液生化学所見:総蛋白 6.4 g/dL、アルブミン 3.8 g/dL、 総ビリルビン 4.8 mg/dL、 直接ビリルビン 0.7 mg/dL、AST 29 U/L、ALT 12 U/L、LD 854 U/L(基準 120~245)。 免疫血清学所見:CRP 0.3 mg/dL、直接 Coombs 試験陰性。この患者の末梢血塗抹 May-Giemsa 染色標本を別に示す。
この患者に合併する可能性が高いのはどれか。 2 つ選べ。
a. 胆石
b. 脾腫
c. 肝硬変
d. 静脈血栓
e. Raynaud 現象